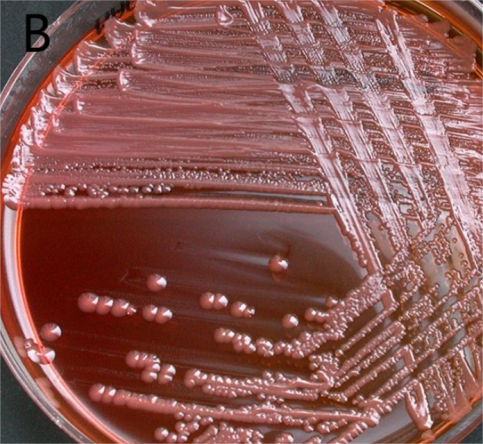

1.柯氏柠檬酸杆菌(Citrobacter koseri)
物种名:柯氏柠檬酸杆菌
拉丁学名:Citrobacter koseri
分类学地位:细菌界Bacteria;变形菌门Proteobacteria;
γ-变形菌纲Gammaproteobacteria;肠杆菌目Enterobacteriales;
肠杆菌科Enterobacteriaceae;枸橼酸杆菌属Citrobacter
柯氏柠檬酸杆菌(Citrobacter koseri),又称差异柠檬酸杆菌(Citrobacter diversus),该菌为条件致病菌,可造成土壤、水、食物等污染。主要导致机体衰竭,免疫功能低下,或患有慢性疾病的患者患病,感染会导致食物中毒、化脓性脑膜炎、脑脓肿、肺炎、泌尿道感染、胆道感染、败血症。
1.1生物学特性
1.1.1培养特征
柯氏柠檬酸杆菌在血平板上菌落直径通常为2-4 nm,光滑、略凸起、湿润半透明或不透明、灰白、表面光泽、边缘整齐(图1A);在MAC平板形成上较小、圆形、略微凸起、粉红色的菌落(图1B)[1]。
图1 柯氏柠檬酸杆菌在各种平板上的培养结果
A:血平板[2],B:MAC平板[2]
1.1.2形态学特征
柯氏柠檬酸杆菌为革兰氏阴性菌,大小为(0.5-0.8) μm×(1.0-3.0) μm,菌体呈杆状,通常是直杆状或略微弯曲状。有鞭毛,可以依靠鞭毛进行运动[1]。

图2 柯氏柠檬酸杆菌扫描电镜照片[2]
1.1.3生化特征
柯氏柠檬酸杆菌能发酵葡萄糖和乳糖,不产生H2S;吲哚试验、柠檬酸盐试验、过氧化氢酶、精氨酸双水解酶、鸟氨酸脱羧酶均为阳性;氧化酶试验阴性。
1.2分布、传播与致病性
1.2.1分布与传播
柯氏柠檬酸杆菌可以通过粪便排泄分散到环境中,例如土壤、水和人类和动物的肠道。细菌可以通过多种途径进入人体,例如摄入受污染的食物或水、吸入受污染的气溶胶或接触受污染的表面或医疗设备。
1.2.2致病性
柯氏柠檬酸杆菌一旦进入体内,可以侵入宿主组织并从感染的初始部位扩散到身体的其他部位。与这种细菌相关的常见感染包括尿路感染(UTI)、血流感染(菌血症)、肺炎、脑膜炎和腹腔内感染。其感染在某些弱势群体中更为常见,例如早产儿、新生儿、老年人和免疫功能低下的患者。在新生儿中,它可能导致严重的感染,例如新生儿败血症和脑膜炎,脑膜炎是一种严重且可能危及生命的中枢神经系统感染。
柯氏柠檬酸杆菌会产生各种毒力因子,进而增强其感染能力。这些因素包括允许细菌粘附在宿主细胞上的粘附素,可促进柯氏柠檬酸杆菌在人类上皮细胞的定植和侵袭。此外,它还会产生毒素和其他导致组织损伤和炎症的因素,如肿瘤坏死因子-α(TNF-α)和白细胞介素-1β(IL-1β),这些分子激活小胶质细胞,导致新生儿和免疫功能低下个体的脑膜炎和脑脓肿[3]。
柯氏柠檬酸杆菌对磺胺类药物、甲氧苄啶、氨基糖苷类、氯霉素、四环素、萘啶酸、氟喹诺酮类、呋喃妥因、多粘菌素和磷霉素敏感,但由于染色体β-内酰胺酶的过表达,通常对头孢菌素耐药[4]。
1.3检测方法
SN/T 2552.6-2010(乳与乳制品卫生微生物学检验方法):将样品直接称量到装有9倍预热到45℃的灭菌蒸馏水的样品稀释瓶中,振摇使样品充分混匀,36℃培养18 h-24 h进行增菌。随后用SS平板和BS平板进行分离培养,采用三区法或四区法划线,以获得单个菌落。将平板倒置于36℃,SS琼脂平板培养18 h-24 h,BS琼脂平板培养40 h-48 h。挑取单菌落进行进行革兰氏染色,氧化酶试验初步生化鉴定。柯氏柠檬酸杆菌柠檬酸盐试验、过氧化氢酶、精氨酸双水解酶、鸟氨酸脱羧酶均为阳性;氧化酶试验阴性[5]。
1.4典型案例
Ekwanzala[6]等在污水处理厂中分离出耐碳青霉烯类的柯氏柠檬酸杆菌,并对该菌株进行了全基因组测序,推测该菌株是人类病原体的概率为0.906。柯氏柠檬酸杆菌常存在于污水环境中,日常生活中需要注意该菌对人类的致病性,尤其是污水处理厂工人更要注意该菌的传播和感染。
Pollara[7]等报道了一例罕见的由柯氏柠檬酸杆菌引起的脑膜炎病例,该病例是一位免疫功能正常的成年人在进行自由潜水后被发现感染该菌,进而近期脑膜炎的发生。自由潜水引起的中耳压力变化以及随后的炎症反应可能为这种环境有机体提供了进入中枢神经系统的机会,从而能够引起具有临床意义的感染。
1.5防治对策
本病可自愈,在饮水中加入硫酸新霉素、四环素可减少损失,但并不能完全消除感染,饮水中加入磺胺类药物也可降低死亡率。改善环境卫生和使用隔离器是最重要的控制方法。
参考文献
[1] 胡建华, 姚明, 崔淑芳. 实验动物学教程. 上海: 上海科学技术出版社, 2009.
[2] https://www.microbe-canvas.com/Bacteria/gram-negative-rods/facultative-anaerobic-3/catalase-positive-3/oxidase-negative/colistin-susceptible-1/citrobacter-koseri.html.
[3] Arısoy AE, Arısoy ES, Bayar Muluk N et al. Hearing Loss in Congenital, Neonatal and Childhood Infections. Springer: Cham, 2023.
[4] Jabeen I, Islam S, Hassan AKMI et al. A brief insight into Citrobacter species – a growing threat to public health. Frontiers in Antibiotics, 2023, 5: 1276982.
[5] SN/T 2552.6-2010 乳及乳制品卫生微生物学检验方法.
[6] Ekwanzala MD, Dewar JB, Kamika I et al. Genome sequence of carbapenem-resistant Citrobacter koseri carrying bla isolated from sewage sludge. J Glob Antimicrob Resist, 2020, 20: 94-97.
[7] Pollara G, Savy L, Cropley I et al. Citrobacter koseri meningitis: another freediving risk? J Infect, 2011, 62: 101-103.
.png)
